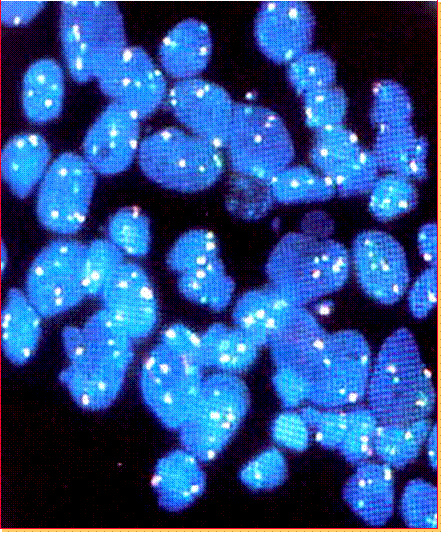

|
|
Actualización:
15 de abril de 2009
|
|
|
|
Diseño
y dirección: Prof. Dra. Silvia F. de Petrino ; Webmaster: Dra.
Mirta Fontenla
|
|
Universidad
Nacional de Tucumán, Facultad de Medicina, Departamento Biomédico,
Orientación Biología- San Miguel de Tucumán, Argentina
Copyright © 2004-2008. http://ar.geocities.com.ar/biolme
|
|
Reproducción
autorizada únicamente con fines educativos citando su origen.
|
|
CITOGENETICA HUMANA : GALERIA DE IMAGENES |
 |
 |
 |
 |
METAFASE CON BANDEO G
 |
 |
 |
 |
 |
 |
|
 |
FISH PARA SECUENCIA ÚNICA DE GENES: SINDROME DE KALLMAN
|
CITOLOGIA:
Microscopía
| Mecanismos
de transporte en la membrana celular
| Matriz Extracelular
| Asociaciones
Celulares | Comunicación
Intercelular | Sistema
de Endomembranas | Retículo
Endoplasmático Liso | Citoesqueleto
| Mitocondrias
| Peroxisomas
| Núcleo
Celular |
Cromosoma | División
Celular | Ciclo
celular | Biología
tumoral |
HIPERTEXTOS:Mitosis
| Meiosis
|
Biología Tumoral |
|
|||||
|
EMBRIOLOGIA:
Gametogénesis
|
Fecundación
|
1º, 2º, 3º
semana del desarrollo
| Período
Embrionario | Período
Fetal | Embriología
Especial
|
|||||